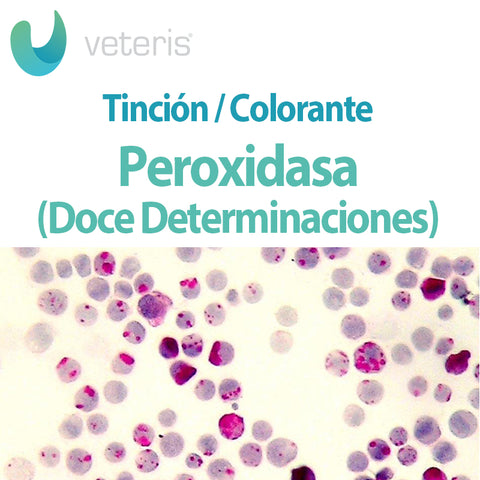
Tinción de Peroxidasa 12 Determinaciones
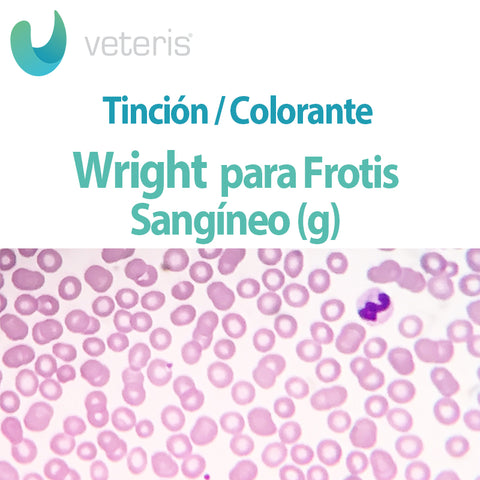
Tinción Wright para Frotis Sangineo

Laboratorio | Nacional
Oferta


Agitadores con placa de calentamiento análogo escolar. Modelo 85-2
85-2 | Nacional
$ 3,392.00
Precio habitual
$ 3,990.00
Tipo de producto
Filtrar por marca
- Adaltis
- ADAM
- Amscope
- Armstrong Medical
- AS Instruments
- Axiovet
- Beurer
- Control Company
- CRM Globe
- CScientific
- Ecoshel
- EsteriUV
- Felisa
- Fith
- Haier
- IMPORTACION
- Long Gene
- Microgyn
- MILWAUKEE
- Mindray Animal Care
- Nacional
- OHAUS
- PLUSLIFE
- RADWAG
- Science Med
- SCIENTASTIC
- Solbat
- Tuk
- Unico
- Velab
- Veteris
- Vinson
- Welch Allyn
Laboratorio